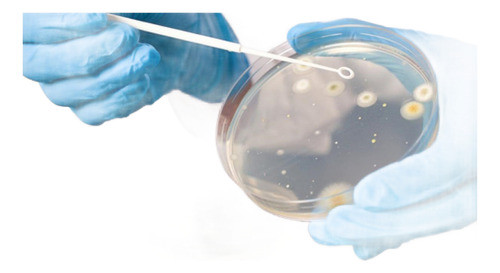
Estudio Análisis Test De Toxicidad O Bioensayos 1

Solvents
Explore our extensive selection of solvents in the Laboratory Chemicals category. Perfect for scientists and industrial professionals, our high-quality solvents are essential for various laboratory applications, including research, analysis, and formulation. Discover premium products that ensure accuracy and reliability in your scientific endeavors.
- Product
- Qty in Cart
- Quantity
- Price
- Subtotal
-

Perfyltech Formaldehyde Solution 3% 1 Liter
US $63.38 & eligible for FREE ShippingShop Formaldeído Solução 3% Fr 1 Litro and more Anilinas at Latinafy.comDiscover the efficiency of Perfyltech's 3% Formaldehyde Solution in a convenient 1-liter bottle. This high-quality solution is perfect for a variety of applications, from laboratory...- SKU:
- MLB1775395351
- Shipping Time:
- Ships within 2-5 business days after your purchase. We will receive your product at our warehouse and carefully package it for international shipping.
- Weight:
- 1.30 KGS
- Origin:
- Brazil
- Vendor:
- Shop on Mercado Libre Brazil
- Brand:
- Perfyltech
US $63.38 & eligible for FREE Shipping -
On Sale

Química Basse Normal Propanol - Alcohol Propílico (x 1 Litro)
Now: US $74.19 & eligible for FREE ShippingWas: US $80.53Shop Normal Propanol - Alcohol Propílico (x 1 Litro) and more Otros at Latinafy.comDiscover Química Basse's Normal Propanol, a high-quality propan-1-ol that is colorless and highly miscible with water. This versatile alcohol is commonly used in a variety...- SKU:
- MLA1495111858
- Shipping Time:
- Ships within 2-5 business days after your purchase. We will receive your product at our warehouse and carefully package it for international shipping.
- Weight:
- 1.30 KGS
- Origin:
- Argentina
- Vendor:
- Shop on Mercado Libre Argentina
- Brand:
- Química Basse
Now: US $74.19 & eligible for FREE ShippingWas: US $80.53Qty in Cart: 0Quantity:Price:Now: US $74.19 & eligible for FREE ShippingWas: US $80.53Subtotal: -


Himedia Agar Grau Bacteriológico 500g
US $248.51 & eligible for FREE ShippingShop Agar Grau Bacteriológico 500g and more Outros at Latinafy.comDiscover the quality of Himedia's Agar Grau Bacteriológico in a convenient 500g packaging. Designed specifically for bacteriological culture media and plant tissue culture, this agar is...- SKU:
- MLB3285449225
- Shipping Time:
- Ships within 2-5 business days after your purchase. We will receive your product at our warehouse and carefully package it for international shipping.
- Weight:
- 0.65 KGS
- Origin:
- Brazil
- Vendor:
- Shop on Mercado Libre Brazil
- Brand:
- Himedia
US $248.51 & eligible for FREE Shipping -

Hanna Nitrite High Range Checker® HI708-25 Reagents
US $289.30 & eligible for FREE ShippingShop Reactivos Nitrito Rango Alto Checker® Hc Hanna Hi708-25 and more Otros at Latinafy.comDiscover the Hanna HI708-25 reagents designed for high-range nitrite measurement. Each pack contains sufficient reagent for 25 precise tests, compatible...- SKU:
- MLA1437163481
- Shipping Time:
- Ships within 2-5 business days after your purchase. We will receive your product at our warehouse and carefully package it for international shipping.
- Weight:
- 0.13 KGS
- Origin:
- Argentina
- Vendor:
- Shop on Mercado Libre Argentina
- Brand:
- Hanna
US $289.30 & eligible for FREE Shipping -
On Sale


Abebashop Percloruro Ferrico 1 Litro Removedor Circuitos-p
Now: US $136.32 & eligible for FREE ShippingWas: US $144.70Shop Percloruro Ferrico 1 Litro Removedor Circuitos-p and more Etiquetas de Tela at Latinafy.comDiscover our concentrated Ferric Chloride solution, perfect for etching and circuit board removal applications. Available in a convenient 1-liter bottle, this...- SKU:
- MLA1736607824
- Shipping Time:
- Ships within 2-5 business days after your purchase. We will receive your product at our warehouse and carefully package it for international shipping.
- Weight:
- 1.95 KGS
- Origin:
- Argentina
- Vendor:
- Shop on Mercado Libre Argentina
- Brand:
- Abebashop
Now: US $136.32 & eligible for FREE ShippingWas: US $144.70Qty in Cart: 0Quantity:Price:Now: US $136.32 & eligible for FREE ShippingWas: US $144.70Subtotal: -


Chemitec Solutions Flux Gel Contaflux Soldering Circuit Assembly Syringe 10cc
US $50.46 & eligible for FREE ShippingShop Flux Gel Contaflux Soldadura Circuito Montaje Jeringa 10cc and more Otros at Latinafy.comExperience precision soldering with the Chemitec Solutions Flux Gel Contaflux in a convenient 10cc syringe. Designed specifically for surface mount circuit...- SKU:
- MLA746066697
- Shipping Time:
- Ships within 2-5 business days after your purchase. We will receive your product at our warehouse and carefully package it for international shipping.
- Weight:
- 0.13 KGS
- Origin:
- Argentina
- Vendor:
- Shop on Mercado Libre Argentina
- Brand:
- Chemitec Solutions
US $50.46 & eligible for FREE Shipping -

Inlab Tween 20 Polysorbate - 500ml
US $79.52 & eligible for FREE ShippingShop Tween 20 Polissorbato - 500ml and more Anilinas at Latinafy.comIntroducing Inlab Tween 20 Polysorbate, an essential ingredient in various formulations. This high-quality 500ml bottle of Tween 20 is designed to enhance the performance of your...- SKU:
- MLB3188925577
- Shipping Time:
- Ships within 2-5 business days after your purchase. We will receive your product at our warehouse and carefully package it for international shipping.
- Weight:
- 0.65 KGS
- Origin:
- Brazil
- Vendor:
- Shop on Mercado Libre Brazil
- Brand:
- Inlab
US $79.52 & eligible for FREE Shipping -
On Sale


Delta 3 Units Conductive Graphite Paint 5cc Resistive
Now: US $56.11 & eligible for FREE ShippingWas: US $59.54Shop 3 Unidades Pintura Grafito Conductora 5cc Resistiva Delta and more Otros at Latinafy.comDiscover the versatility of Delta's Conductive Graphite Paint, perfect for a wide range of applications. Each pack contains three 5cc units, specifically...- SKU:
- MLA1343639181
- Shipping Time:
- Ships within 2-5 business days after your purchase. We will receive your product at our warehouse and carefully package it for international shipping.
- Weight:
- 0.07 KGS
- Origin:
- Argentina
- Vendor:
- Shop on Mercado Libre Argentina
- Brand:
- Delta
Now: US $56.11 & eligible for FREE ShippingWas: US $59.54Qty in Cart: 0Quantity:Price:Now: US $56.11 & eligible for FREE ShippingWas: US $59.54Subtotal: -


Delivery de Productos Quimicos Limpia Llanta - Descontaminante Ferrico - 20lt De Fabrica
US $589.71 & eligible for FREE ShippingShop Limpia Llanta - Descontaminante Ferrico - 20lt De Fabrica and more Desengrasantes at Latinafy.comDiscover the power of Delivery de Productos Quimicos Limpia Llanta, designed specifically for heavy-duty wheel cleaning. This aqueous solution...- SKU:
- MLA1866217086
- Shipping Time:
- Ships within 2-5 business days after your purchase. We will receive your product at our warehouse and carefully package it for international shipping.
- Weight:
- 29.38 KGS
- Origin:
- Argentina
- Vendor:
- Shop on Mercado Libre Argentina
- Brand:
- Delivery De Productos Quimicos
US $589.71 & eligible for FREE Shipping -

DOCALAB Toxicity Analysis Study or Bioassays
US $134.54 & eligible for FREE ShippingShop Estudio Análisis Test De Toxicidad O Bioensayos and more Otros at Latinafy.comIntroducing the DOCALAB Toxicity Analysis Study, a robust examination of a specific product or substrate's impact on seedlings, specifically lettuce (Lactuca sativa). This...- SKU:
- MLA1844050134
- Shipping Time:
- Ships within 2-5 business days after your purchase. We will receive your product at our warehouse and carefully package it for international shipping.
- Weight:
- 0.65 KGS
- Origin:
- Argentina
- Vendor:
- Shop on Mercado Libre Argentina
- Brand:
- Docalab
US $134.54 & eligible for FREE Shipping -
On Sale


Koube 3 Concentrated Additives + 3L Deionized Water
Now: US $146.38 & eligible for FREE ShippingWas: US $158.32Shop 3 Aditivo Concentrado Rosa + 3l Água Desmineralizada Koube and more Aditivos at Latinafy.comDiscover the ultimate cooling solution with the Koube kit, featuring three 1-liter bottles of concentrated synthetic additives and a 3-liter gallon of...- SKU:
- MLB3406991649
- Shipping Time:
- Ships within 2-5 business days after your purchase. We will receive your product at our warehouse and carefully package it for international shipping.
- Weight:
- 5.85 KGS
- Origin:
- Brazil
- Vendor:
- Shop on Mercado Libre Brazil
- Brand:
- Koube Quimicos
Now: US $146.38 & eligible for FREE ShippingWas: US $158.32Qty in Cart: 0Quantity:Price:Now: US $146.38 & eligible for FREE ShippingWas: US $158.32Subtotal: -


MAK Power Floc X 1 Liter Flocculant Decanting Agent
US $79.49 & eligible for FREE ShippingShop Clarificador Mak Power Floc X 1 Litro Floculante Decantador and more Alguicidas para Piletas at Latinafy.comIntroducing MAK POWER Floc in a convenient 1-liter bottle, the ultimate flocculant and clarifier designed for professional use. This...- SKU:
- MLA1702537452
- Shipping Time:
- Ships within 2-5 business days after your purchase. We will receive your product at our warehouse and carefully package it for international shipping.
- Weight:
- 1.30 KGS
- Origin:
- Argentina
- Vendor:
- Shop on Mercado Libre Argentina
- Brand:
- Makinthal
US $79.49 & eligible for FREE Shipping -
On Sale

ANCAP Industrial Alcohol 99.9% Cleaning 10 Liters
Now: US $216.19 & eligible for FREE ShippingWas: US $235.02Shop Alcohol Industrial Ancap 99.9% Limpieza 10 Litros and more Otros at Latinafy.comIntroducing the ANCAP Industrial Alcohol, a premium cleaning solution boasting an impressive 99.9% purity. This 10-liter container is designed for both home and...- SKU:
- MLU471065015
- Shipping Time:
- Ships within 2-5 business days after your purchase. We will receive your product at our warehouse and carefully package it for international shipping.
- Weight:
- 13.00 KGS
- Origin:
- Uruguay
- Vendor:
- Shop on Mercado Libre Uruguay
- Brand:
- Ancap
Now: US $216.19 & eligible for FREE ShippingWas: US $235.02Qty in Cart: 0Quantity:Price:Now: US $216.19 & eligible for FREE ShippingWas: US $235.02Subtotal: -
On Sale


Química Basse Lauril Etoxilado 70% - Less - (x 20 Kilos)
Now: US $634.03 & eligible for FREE ShippingWas: US $692.06Shop Lauril Etoxilado 70% - Less - (x 20 Kilos) and more Jabón para Ropa at Latinafy.comQuímica Basse Lauril Etoxilado 70% is an effective anionic detergent that works well in both acidic and basic environments, as well as in hard water. This powerful...- SKU:
- MLA1385766795
- Shipping Time:
- Ships within 2-5 business days after your purchase. We will receive your product at our warehouse and carefully package it for international shipping.
- Weight:
- 26.00 KGS
- Origin:
- Argentina
- Vendor:
- Shop on Mercado Libre Argentina
- Brand:
- Química Basse
Now: US $634.03 & eligible for FREE ShippingWas: US $692.06Qty in Cart: 0Quantity:Price:Now: US $634.03 & eligible for FREE ShippingWas: US $692.06Subtotal: -


Styrene Monomer 500 ml
US $58.34 & eligible for FREE ShippingShop Monomero De Estireno X Medio Litro. and more Otros at Latinafy.comDiscover the excellent quality of Styrene Monomer, packaged in a convenient 500 ml bottle. This product is brand new and ready for immediate use in various applications. Styrene...- SKU:
- MLA776388363
- Shipping Time:
- Ships within 2-5 business days after your purchase. We will receive your product at our warehouse and carefully package it for international shipping.
- Weight:
- 0.65 KGS
- Origin:
- Argentina
- Vendor:
- Shop on Mercado Libre Argentina
- Brand:
- Unbranded
US $58.34 & eligible for FREE Shipping -
On Sale

Quimisul Etilenoglicol (Mono) 1 Liter
Now: US $64.98 & eligible for FREE ShippingWas: US $69.07Shop Etilenoglicol ( Mono ) 1 Litro and more Protetores Labiais at Latinafy.comDiscover the power of Quimisul Etilenoglicol in a convenient 1-liter bottle. This monoethylene glycol is perfect for various applications, thanks to its colorless and...- SKU:
- MLB2722325221
- Shipping Time:
- Ships within 2-5 business days after your purchase. We will receive your product at our warehouse and carefully package it for international shipping.
- Weight:
- 1.30 KGS
- Origin:
- Brazil
- Vendor:
- Shop on Mercado Libre Brazil
- Brand:
- Quimisul
Now: US $64.98 & eligible for FREE ShippingWas: US $69.07Qty in Cart: 0Quantity:Price:Now: US $64.98 & eligible for FREE ShippingWas: US $69.07Subtotal: -
On Sale

TORT Alcohol Isopropilico - 5 Litro - 99.9 Pureza
Now: US $143.86 & eligible for FREE ShippingWas: US $155.39Shop Alcohol Isopropilico - 5 Litro - 99.9 Pureza and more Otros at Latinafy.comExperience the unparalleled purity of our high-quality Isopropyl Alcohol, formulated to deliver exceptional cleaning results. With a purity level of 99.9%, it is perfectly...- SKU:
- MLU471215507
- Shipping Time:
- Ships within 2-5 business days after your purchase. We will receive your product at our warehouse and carefully package it for international shipping.
- Weight:
- 6.50 KGS
- Origin:
- Uruguay
- Vendor:
- Shop on Mercado Libre Uruguay
- Brand:
- Tort
Now: US $143.86 & eligible for FREE ShippingWas: US $155.39Qty in Cart: 0Quantity:Price:Now: US $143.86 & eligible for FREE ShippingWas: US $155.39Subtotal: -
On Sale


Elego Photopolymer Resin for 3D LCD Printing
Now: US $273.73 & eligible for FREE ShippingWas: US $297.47Shop Elego Resina De Polímero Fotopolímero Para Impresión 3d Lcd and more Archivos STL at Latinafy.comDiscover the Elego Photopolymer Resin, designed specifically for 3D LCD printing. This high-quality resin operates at a wavelength of 405 nm, ensuring...- SKU:
- MLU664794836
- Shipping Time:
- Ships within 2-5 business days after your purchase. We will receive your product at our warehouse and carefully package it for international shipping.
- Weight:
- 1.30 KGS
- Origin:
- Uruguay
- Vendor:
- Shop on Mercado Libre Uruguay
- Brand:
- Elego
Now: US $273.73 & eligible for FREE ShippingWas: US $297.47Qty in Cart: 0Quantity:Price:Now: US $273.73 & eligible for FREE ShippingWas: US $297.47Subtotal: -
On Sale


Caflab Decolorant for Gram Staining - 100 ml
Mrsp: US $50.08Now: US $49.87 & eligible for FREE ShippingWas: US $55.15Shop Decolorante ( Para Tinción De Gram ) - 100 Ml - Caflab and more Frascos con Gotero at Latinafy.comCaflab's Decolorant for Gram Staining is an essential reagent for any microbiology laboratory. With a convenient 100 ml plastic dropper bottle, this...- SKU:
- MLA1139589227
- Shipping Time:
- Ships within 2-5 business days after your purchase. We will receive your product at our warehouse and carefully package it for international shipping.
- Weight:
- 0.13 KGS
- Origin:
- Argentina
- Vendor:
- Shop on Mercado Libre Argentina
- Brand:
- Caflab
Mrsp: US $50.08Now: US $49.87 & eligible for FREE ShippingWas: US $55.15Qty in Cart: 0Quantity:Price:Mrsp: US $50.08Now: US $49.87 & eligible for FREE ShippingWas: US $55.15Subtotal: -


Nameco Propylene Glycol - 5 Liters
US $283.23 & eligible for FREE ShippingShop Propilenglicol - 5 Litros and more Otros at Latinafy.comWith over 40 years of experience in the market, we bring you high-quality propylene glycol. This medium molecular weight glycol is clear, colorless, and slightly viscous, making it ideal for...- SKU:
- MLA1110093886
- Shipping Time:
- Ships within 2-5 business days after your purchase. We will receive your product at our warehouse and carefully package it for international shipping.
- Weight:
- 6.50 KGS
- Origin:
- Argentina
- Vendor:
- Shop on Mercado Libre Argentina
- Brand:
- Nameco
US $283.23 & eligible for FREE Shipping -


San Francisco IPA Isopropyl Alcohol Maxima Pureza 5 Lts. Evaporacion Desengrasa
US $234.19 & eligible for FREE ShippingShop Ipa Isopropilico Maxima Pureza 5 Lts. Evaporacion Desengrasa and more Aguas Minerales at Latinafy.comExperience the superior cleaning power of San Francisco's IPA Isopropyl Alcohol, featuring high purity and rapid evaporation. This exceptional...- SKU:
- MLA1512799626
- Shipping Time:
- Ships within 2-5 business days after your purchase. We will receive your product at our warehouse and carefully package it for international shipping.
- Weight:
- 6.50 KGS
- Origin:
- Argentina
- Vendor:
- Shop on Mercado Libre Argentina
- Brand:
- San Francisco
US $234.19 & eligible for FREE Shipping -


V.O Agua Desmineralizada 5 Litros
US $127.52 & eligible for FREE ShippingShop Agua Desmineralizada 5 Litros and more Otros at Latinafy.comExperience the purity of V.O Water, meticulously distilled for your diverse needs. This 5-liter bidistilled demineralized water adheres to Analar standards, ensuring high quality for...- SKU:
- MLA1130361586
- Shipping Time:
- Ships within 2-5 business days after your purchase. We will receive your product at our warehouse and carefully package it for international shipping.
- Weight:
- 6.50 KGS
- Origin:
- Argentina
- Vendor:
- Shop on Mercado Libre Argentina
- Brand:
- V.O
US $127.52 & eligible for FREE Shipping -


Generic 99.99% Pure Liquid Gallium Metal
US $131.28 & eligible for FREE ShippingShop 99.99% Líquido Gálio Puro Líquido Gálio Elemento Metáli and more Moldes para Injetoras at Latinafy.comExperience the unique characteristics of 99.99% pure liquid gallium metal. This innovative material is safe to handle, non-toxic, and perfect for...- SKU:
- MLB3516527963
- Shipping Time:
- Ships within 2-5 business days after your purchase. We will receive your product at our warehouse and carefully package it for international shipping.
- Weight:
- 0.22 KGS
- Origin:
- Brazil
- Vendor:
- Shop on Mercado Libre Brazil
- Brand:
- Generic
US $131.28 & eligible for FREE Shipping -
On Sale

Quimisul Dióxido De Sílicio 500g - Sílica Precipitada
Now: US $72.82 & eligible for FREE ShippingWas: US $76.82Shop Dioxido De Sílicio 500g - Sílica Precipitada and more Talco at Latinafy.comDiscover the exceptional properties of Quimisul Dióxido De Sílicio. This 500g unit of precipitated silica is a high-quality product designed for various applications. With...- SKU:
- MLB2722336939
- Shipping Time:
- Ships within 2-5 business days after your purchase. We will receive your product at our warehouse and carefully package it for international shipping.
- Weight:
- 0.65 KGS
- Origin:
- Brazil
- Vendor:
- Shop on Mercado Libre Brazil
- Brand:
- Quimisul
Now: US $72.82 & eligible for FREE ShippingWas: US $76.82Qty in Cart: 0Quantity:Price:Now: US $72.82 & eligible for FREE ShippingWas: US $76.82Subtotal: -

Aldon Eosine B Solution 1% 30 Ml Laboratory
US $186.82 & eligible for FREE ShippingShop Solucion Eosina B Al 1% Botella 30 Ml Laboratorio Educativo and more Otros at Latinafy.comIntroducing Aldon Eosine B Solution, a 1% aqueous dye used in histological and cytological staining techniques. This essential reagent imparts a vivid red-pink...- SKU:
- MLA1832884586
- Shipping Time:
- Ships within 2-5 business days after your purchase. We will receive your product at our warehouse and carefully package it for international shipping.
- Weight:
- 0.07 KGS
- Origin:
- Argentina
- Vendor:
- Shop on Mercado Libre Argentina
- Brand:
- Aldon
US $186.82 & eligible for FREE Shipping -
On Sale


Grafisur Control of Narcotics Book - Pharmacies - Laboratories
Now: US $167.78 & eligible for FREE ShippingWas: US $179.81Shop Libro Control De Estupefacientes - Farmacias - Laboratorios and more Otros at Latinafy.comIntroducing the Grafisur Control of Narcotics Book, designed specifically for pharmacies and laboratories. This manual features a well-structured lined format...- SKU:
- MLA1426603765
- Shipping Time:
- Ships within 2-5 business days after your purchase. We will receive your product at our warehouse and carefully package it for international shipping.
- Weight:
- 0.65 KGS
- Origin:
- Argentina
- Vendor:
- Shop on Mercado Libre Argentina
- Brand:
- Grafisur
Now: US $167.78 & eligible for FREE ShippingWas: US $179.81Qty in Cart: 0Quantity:Price:Now: US $167.78 & eligible for FREE ShippingWas: US $179.81Subtotal: -


Neon Triton-X 100 Com Laudo De Pureza 500ml
US $110.35 & eligible for FREE ShippingShop Triton-x 100 Com Laudo De Pureza 500ml and more Outros at Latinafy.comDiscover the exceptional quality of Neon Triton X 100 in a 500ml bottle. This product stands out due to its high purity and rigorous quality control measures. Manufactured by a...- SKU:
- MLB3288758229
- Shipping Time:
- Ships within 2-5 business days after your purchase. We will receive your product at our warehouse and carefully package it for international shipping.
- Weight:
- 0.65 KGS
- Origin:
- Brazil
- Vendor:
- Shop on Mercado Libre Brazil
- Brand:
- Neon
US $110.35 & eligible for FREE Shipping -

Química Basse Butilglicol (1 Liter)
US $85.46 & eligible for FREE ShippingShop Butilglicol (x 1 Litro) and more Otros at Latinafy.comButilglicol is a clear, sweet-smelling organic compound that belongs to the glycol ether family. This economical and relatively non-volatile solvent serves numerous household and industrial...- SKU:
- MLA1490382886
- Shipping Time:
- Ships within 2-5 business days after your purchase. We will receive your product at our warehouse and carefully package it for international shipping.
- Weight:
- 1.30 KGS
- Origin:
- Argentina
- Vendor:
- Shop on Mercado Libre Argentina
- Brand:
- Química Basse
US $85.46 & eligible for FREE Shipping -


Delta Contacflux Gel Circuit Assembly 10cc x 6 Units
US $65.30 & eligible for FREE ShippingShop Contacflux Gel Delta Flux Circuito Montaje 10cc X 6 Unidades and more Otros at Latinafy.comIntroducing Delta's Contacflux Gel, designed specifically for surface mount circuit soldering. Each syringe contains 10cc of this powerful flux, making it...- SKU:
- MLA790963490
- Shipping Time:
- Ships within 2-5 business days after your purchase. We will receive your product at our warehouse and carefully package it for international shipping.
- Weight:
- 0.20 KGS
- Origin:
- Argentina
- Vendor:
- Shop on Mercado Libre Argentina
- Brand:
- Electroquimica Delta
US $65.30 & eligible for FREE Shipping -


Dinámica Oleato De Etila 1 Liter + 1 Liter BB + 1 Liter BA
US $349.76 & eligible for FREE ShippingShop Oleato De Etila 1 Litro + 1 Litro Ba + 1 Litro Bb and more Anilinas at Latinafy.comDiscover the exceptional quality of Dinámica's Oleato De Etila, available in a convenient 1-liter size. This set also includes 1 liter of BB and 1 liter of BA, making...- SKU:
- MLB3293262759
- Shipping Time:
- Ships within 2-5 business days after your purchase. We will receive your product at our warehouse and carefully package it for international shipping.
- Weight:
- 3.90 KGS
- Origin:
- Brazil
- Vendor:
- Shop on Mercado Libre Brazil
- Brand:
- Dinámica
US $349.76 & eligible for FREE Shipping -
On Sale


Formlabs Clear Resin Cartucho Flgpc04 1L
Now: US $493.12 & eligible for FREE ShippingWas: US $522.00Shop Cartucho Formlabs Flgpc04 Resina Transparente 1l Resin Clear and more Cartuchos de tinta at Latinafy.comDiscover the capabilities of Formlabs Clear Resin, specially formulated for 3D printing. Create robust prototypes and intricate designs that...- SKU:
- MLU630944367
- Shipping Time:
- Ships within 2-5 business days after your purchase. We will receive your product at our warehouse and carefully package it for international shipping.
- Weight:
- 1.43 KGS
- Origin:
- Uruguay
- Vendor:
- Shop on Mercado Libre Uruguay
- Brand:
- Formlabs
Now: US $493.12 & eligible for FREE ShippingWas: US $522.00Qty in Cart: 0Quantity:Price:Now: US $493.12 & eligible for FREE ShippingWas: US $522.00Subtotal: -
On Sale

Exodo Acrilamida 99% Ps 500g
Now: US $112.19 & eligible for FREE ShippingWas: US $119.57Shop Acrilamida 99% Ps 500g and more Anilinas at Latinafy.comDiscover the high-purity Exodo Acrilamida at 99%, specifically formulated for professionals seeking reliable and effective results. This 500g package ensures you have enough material for your...- SKU:
- MLB2722299475
- Shipping Time:
- Ships within 2-5 business days after your purchase. We will receive your product at our warehouse and carefully package it for international shipping.
- Weight:
- 0.65 KGS
- Origin:
- Brazil
- Vendor:
- Shop on Mercado Libre Brazil
- Brand:
- Exodo
Now: US $112.19 & eligible for FREE ShippingWas: US $119.57Qty in Cart: 0Quantity:Price:Now: US $112.19 & eligible for FREE ShippingWas: US $119.57Subtotal: -


Abreu Quimica Hexano Puro 1 Litro
US $75.54 & eligible for FREE ShippingShop Hexano Puro 1 Litro and more Anilinas at Latinafy.comIntroducing Abreu Quimica Hexano, a premium quality solvent available in a convenient 1-liter package. Derived from the fractional distillation of crude oil, Hexano is the go-to choice for various...- SKU:
- MLB3400342201
- Shipping Time:
- Ships within 2-5 business days after your purchase. We will receive your product at our warehouse and carefully package it for international shipping.
- Weight:
- 1.30 KGS
- Origin:
- Brazil
- Vendor:
- Shop on Mercado Libre Brazil
- Brand:
- Abreu Quimica
US $75.54 & eligible for FREE Shipping -
On Sale


Silcril Monomer 100 Ml + Polymer 50 Gr + File + Primer
Now: US $104.85 & eligible for FREE ShippingWas: US $116.37Shop Monomero X 100 Ml + Polimero 50 Gr + Lima + Primer. and more Otros at Latinafy.comDiscover the ultimate nail sculpting kit with the Silcril product line. This comprehensive kit includes a 100 ml normal drying monomer and a versatile 50 g polymer...- SKU:
- MLA741639727
- Shipping Time:
- Ships within 2-5 business days after your purchase. We will receive your product at our warehouse and carefully package it for international shipping.
- Weight:
- 0.33 KGS
- Origin:
- Argentina
- Vendor:
- Shop on Mercado Libre Argentina
- Brand:
- Silcril
Now: US $104.85 & eligible for FREE ShippingWas: US $116.37Qty in Cart: 0Quantity:Price:Now: US $104.85 & eligible for FREE ShippingWas: US $116.37Subtotal: -
On Sale


Icasa Formaldehyde Formol 40% Pure 10 Liters
Now: US $319.84 & eligible for FREE ShippingWas: US $351.79Shop Formaldehído Formol 40% De Pureza X 10 Lt Icasa Pr and more Otros at Latinafy.comIcasa's Formaldehyde (Formol 40%) is an essential organic compound widely used in the chemical industry. It is primarily utilized for preserving biological specimens...- SKU:
- MLA1572313294
- Shipping Time:
- Ships within 2-5 business days after your purchase. We will receive your product at our warehouse and carefully package it for international shipping.
- Weight:
- 13.00 KGS
- Origin:
- Argentina
- Vendor:
- Shop on Mercado Libre Argentina
- Brand:
- Icasa
Now: US $319.84 & eligible for FREE ShippingWas: US $351.79Qty in Cart: 0Quantity:Price:Now: US $319.84 & eligible for FREE ShippingWas: US $351.79Subtotal: -
On Sale

VIDA Biotecnologia Enzymatic Cholesterol Reagent 200ml for Laboratory
Now: US $111.84 & eligible for FREE ShippingWas: US $121.41Shop Reagente Colesterol Enzimatico 200ml Para Laboratorio and more Kits de Criminologia at Latinafy.comThe VIDA Biotecnologia Enzymatic Cholesterol Reagent is a vital component for laboratory analysis, designed to accurately determine total cholesterol...- SKU:
- MLB3705638851
- Shipping Time:
- Ships within 2-5 business days after your purchase. We will receive your product at our warehouse and carefully package it for international shipping.
- Weight:
- 0.65 KGS
- Origin:
- Brazil
- Vendor:
- Shop on Mercado Libre Brazil
- Brand:
- Vida
Now: US $111.84 & eligible for FREE ShippingWas: US $121.41Qty in Cart: 0Quantity:Price:Now: US $111.84 & eligible for FREE ShippingWas: US $121.41Subtotal: -


Total Glacelf Inorganic Refrigerant 1 L
US $70.61 & eligible for FREE ShippingShop Refrigerante Total Glacelf Concentrado Inorganico X1 L and more Refrigerante y Anticongelante at Latinafy.comOur Total Glacelf Inorganic Refrigerant offers exceptional cooling performance for your vehicle. This product is perfect for those looking...- SKU:
- MLA879366401
- Shipping Time:
- Ships within 2-5 business days after your purchase. We will receive your product at our warehouse and carefully package it for international shipping.
- Weight:
- 1.30 KGS
- Origin:
- Argentina
- Vendor:
- Shop on Mercado Libre Argentina
- Brand:
- Total
US $70.61 & eligible for FREE Shipping -

Alur Alcohol 99% - 10 Liters Factory Sealed
US $238.70 & eligible for FREE ShippingShop Alcohol Al 99, Sellado De Fabrica Bidones De 10 Litros and more Otros at Latinafy.comDiscover the high purity of Alur Alcohol at 99.86%, expertly produced at our Paysandu plant. This reliable alcohol is perfect for a variety of applications, and...- SKU:
- MLU470723292
- Shipping Time:
- Ships within 2-5 business days after your purchase. We will receive your product at our warehouse and carefully package it for international shipping.
- Weight:
- 13.00 KGS
- Origin:
- Uruguay
- Vendor:
- Shop on Mercado Libre Uruguay
- Brand:
- Alur
US $238.70 & eligible for FREE Shipping -


DNK Fresh Long Life Liquid Refrigerant 1 Liter for Dilution Yellow 3
US $66.16 & eligible for FREE ShippingShop Liquido Refrigerante Auto 1 Litro Para Diluir Amarillo and more Refrigerante y Anticongelante at Latinafy.comIntroducing DNK Fresh Long Life Liquid Refrigerant, a universal coolant that comes in a convenient 1-liter bottle designed for dilution...- SKU:
- MLU600445166
- Shipping Time:
- Ships within 2-5 business days after your purchase. We will receive your product at our warehouse and carefully package it for international shipping.
- Weight:
- 1.30 KGS
- Origin:
- Uruguay
- Vendor:
- Shop on Mercado Libre Uruguay
- Brand:
- Dnk Fresh
US $66.16 & eligible for FREE Shipping -
On Sale


Eisco 500cc Green Methanol Label Bottle
Now: US $83.25 & eligible for FREE ShippingWas: US $89.52Shop Piseta De 500cc Verde Etiqueta Methanol and more Frascos con Gotero at Latinafy.comIntroducing the Eisco 500cc Green Bottle, designed specifically for lab and cleaning purposes. This versatile washing bottle features a bright green color and a...- SKU:
- MLA934277883
- Shipping Time:
- Ships within 2-5 business days after your purchase. We will receive your product at our warehouse and carefully package it for international shipping.
- Weight:
- 0.26 KGS
- Origin:
- Argentina
- Vendor:
- Shop on Mercado Libre Argentina
- Brand:
- Eisco
Now: US $83.25 & eligible for FREE ShippingWas: US $89.52Qty in Cart: 0Quantity:Price:Now: US $83.25 & eligible for FREE ShippingWas: US $89.52Subtotal:
